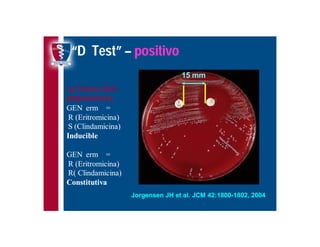
Antibioticoterapia y resistencia microbiana
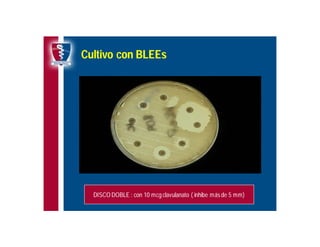
Antibioticoterapia y resistencia microbiana

Incrustar presentación

















































El documento aborda la resistencia microbiana a los antibióticos y destaca los 12 mandamientos del CDC para su control. Se comentan detalles sobre las farmacodinamias y farmacocinéticas de diferentes antibióticos, incluyendo la tigeciclina, y su eficacia frente a patógenos. Además, se analizan los mecanismos de resistencia asociados, especialmente en especies como MRSA y bacterias gram negativas.